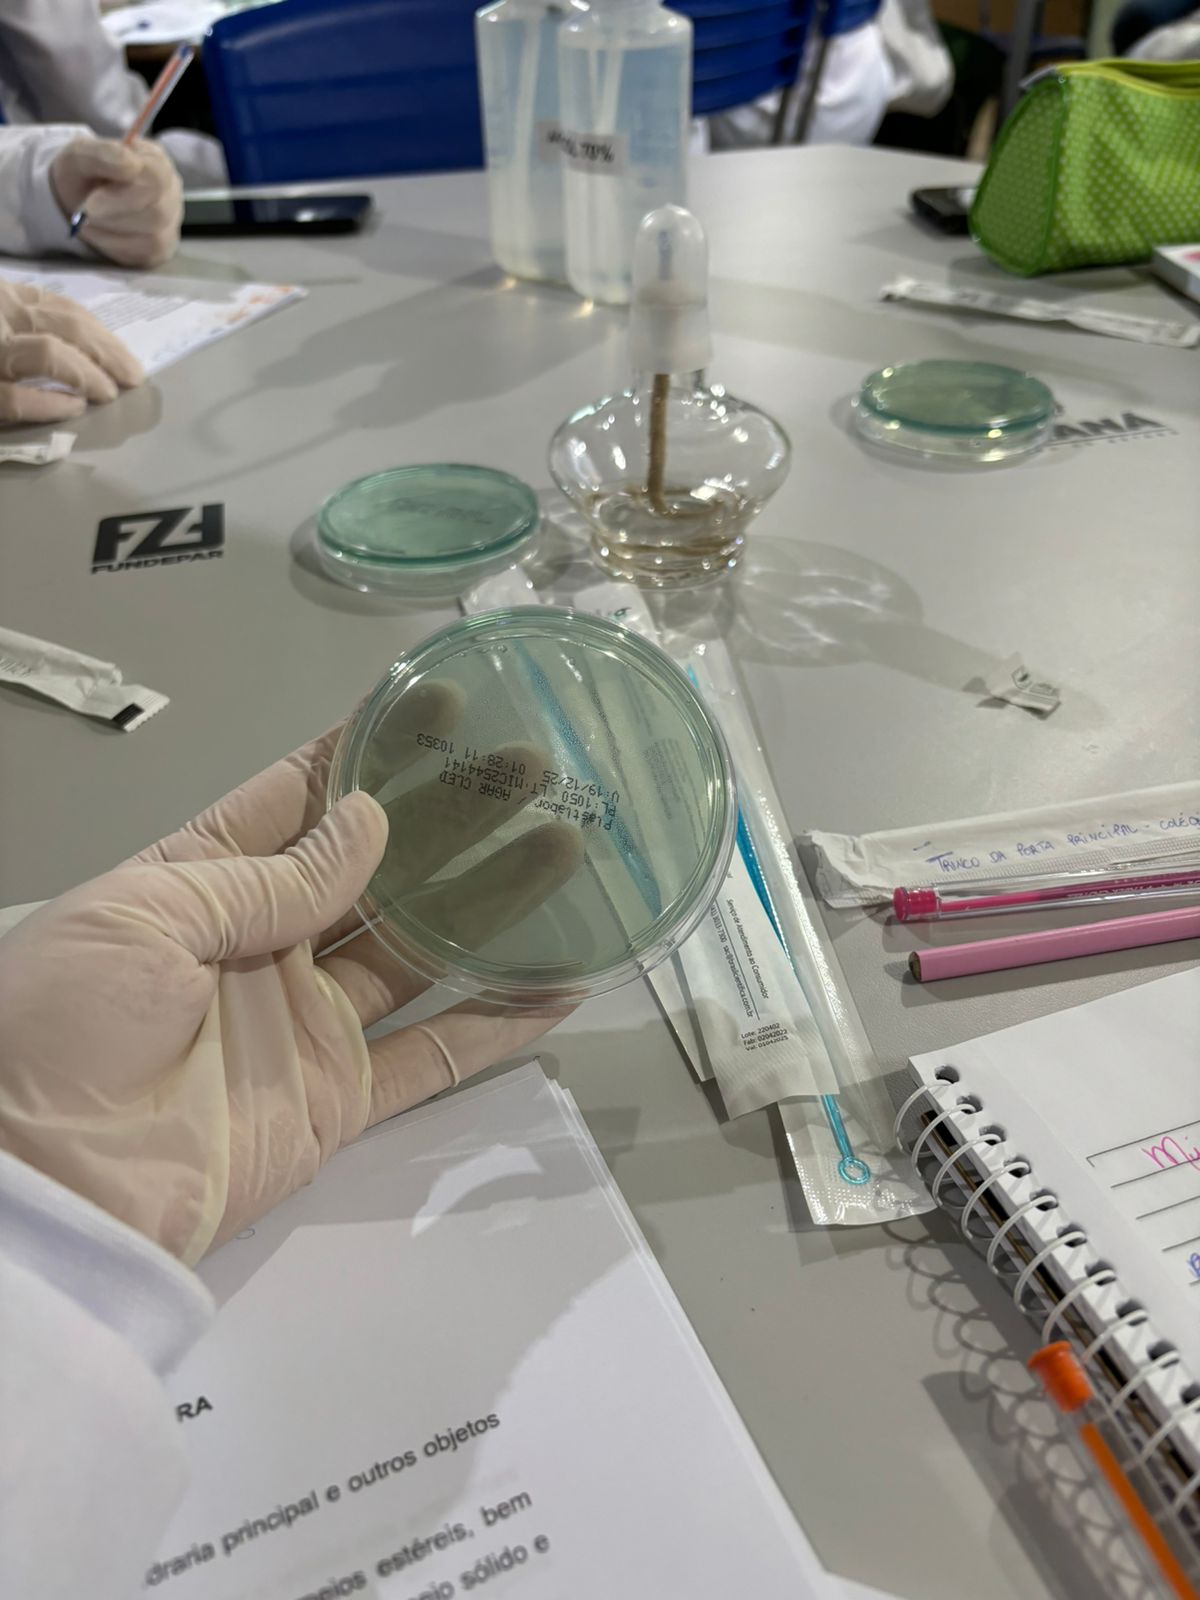

Acontece na UniGuairacá
Polos EAD UniGuairacá realizam aulas práticas dos cursos de saúde
Os alunos de Pinhão e Prudentópolis tiveram aulas de microbiologia e imunologia.
Por: Viviane Moreira
- 12/11/2025 14h25
Nos últimos dias, os polos EAD da UniGuairacá Centro Universitário das cidades de Pinhão de Prudentópolis realizaram uma série de aulas práticas dos cursos de saúde, sendo microbiologia e imunologia. “Lugar tranquilo e agradável para trabalhar, estrutura boa e que atende todos os requisitos para uma melhor comodidade para a execução das aulas práticas e também realização de trabalhos e provas dos alunos. Vale ressaltar também a competência e compromisso do gestor do polo e seus funcionários”, comenta o Professor/laboratorista, Justiniano Berezoski, do polo Pinhão.
Veja também
- Toda História começa com uma Escolha: UniGuairacá lança Vestibular 2026.2
- Dupla conquista: docente de Tecnologia da UniGuairacá participa de conferência internacional e defende dissertação de Mestrado
- Biomedicina UniGuairacá torna pública abertura de inscrições de cadastro reserva para professor não titular
- Conquista UniGuairacá: professora Roberta Gessa defende tese de Doutorado
As aulas foram muito produtivas e os acadêmicos elogiaram muito o atendimento, o ensino, a estrutura dos polos e os docentes. Sempre prezando por uma educação de qualidade, a UniGuairacá leva o conhecimento e o ensino prático a todos os polos de educação à distância.
Vestibular 2026:
A UniGuairacá Centro Universitário está com inscrições abertas para ingresso na instituição em 2026. São mais de 20 cursos presenciais, englobando diferentes áreas da saúde, tecnologia e gestão. As inscrições são gratuitas e devem ser feitas através do link.
A instituição conta com dezenas de salas, todas equipadas com retroprojetores e toda a estrutura que os alunos precisam para atender suas necessidades. Nos laboratórios, os estudantes encontram o que há de mais moderno para as práticas das disciplinas. Entre eles, o laboratório de metodologias inovadoras; o da anatomia; o de práticas odontológicas; o de microbiologia e botânica; citologia e histologia; química e bioquímica; microbiologia e ainda os focados nos cursos da saúde e estética e cosmética. Além disso, o Centro Universitário também mantém em sua infraestrutura uma biblioteca, ginásio poliesportivo, sala de criatividade, sala 3D e restaurante, tudo planejado e organizado.